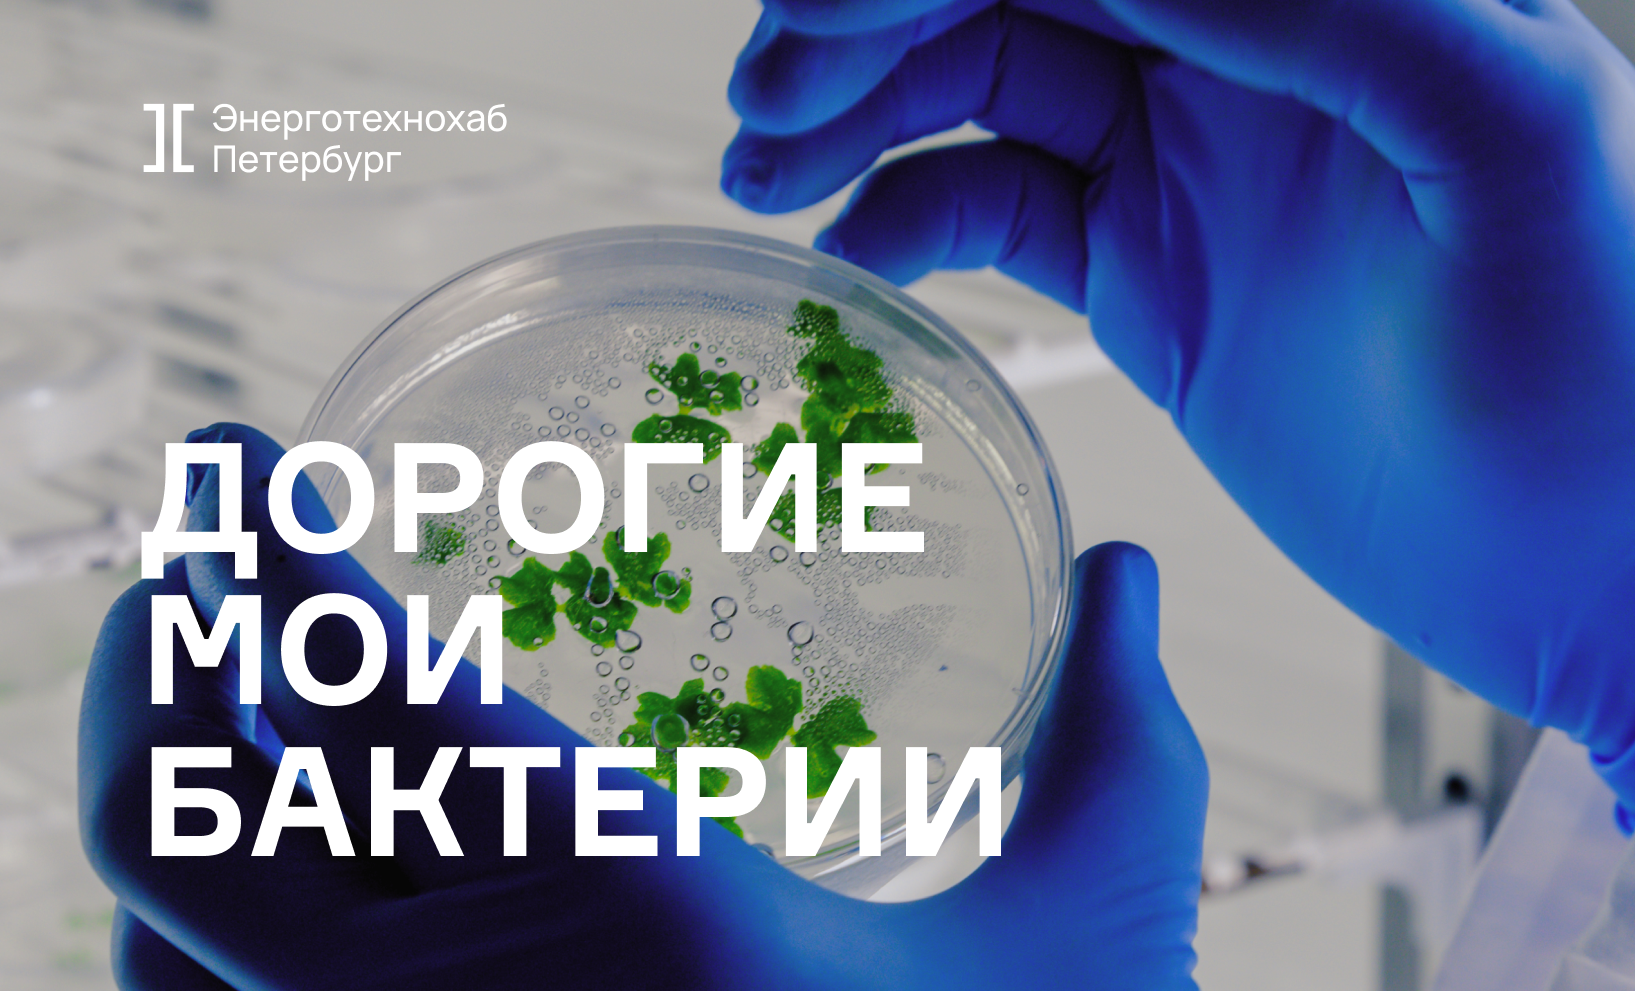

Участник «Энерготехнохаба Петербург» – о технологии по переработке органических отходов
Энерготехнохаб Петербург
Александр Чеканов, генеральный директор компании «Эко Энерджи», точно знает, как сделать из отходов электроэнергию – в этом ему помогают бактерии. Приручает микроорганизмы и производит заветные киловатты Александр вместе с командой исследователей и «Энерготехнохабом Петербург».
Даже у бактерий есть диета (а у тебя?)
В периметре «Энерготехнохаба Петербург» проект «Эко Энерджи» появился еще летом 2022 года. Тогда команда презентовала свой проект в финале состязания конкурса стартапов EnergyHUB, который «Энерготехнохаб Петербург» проводил на базе университета ИТМО. На суд жюри представили идею переработки органических отходов с помощью специальных технологичных контейнеров, в которых обитают бактерии. Для них органика (в основном остатки пищи) – деликатес. Перерабатывая отходы, бактерии улавливают метан и превращают его в биогаз, который сжигается в генераторе и превращается в электроэнергию. Поэтому у такого метода есть и полезный «побочный» эффект – бонусные киловатты.
Правда, как выяснилось, разные бактерии любят разную пищу. Кто-то активно взаимодействует с овощами и фруктами, кто-то берется за мясо и рыбу. Прямо сейчас команда «Эко Энерджи» занимается составлением большого каталога, где будет прописана «специализация» около 50 разных видов микроорганизмов, что поможет населять ими контейнеры, ориентируясь на специфику заказчика.
Полиэтилен равно клиентоориентированность
Как говорит генеральный директор «Эко Энерджи» Александр Чеканов, утилизация органических отходов – задача, актуальная для каждой страны. Эффективные способы ее решения ищут ученые и в Азии, и в Европе. Правда, упор делают на разное. Ставят в приоритет или функциональность, или надежность. «Эко Энерджи» проанализировала все существующие подобные технологии и готова предложить лучшее решение.
К команде уже обращались с вопросом, можно ли в чудо-контейнерах переработать что-то неорганическое, например, полиэтилен. И это случай, когда стартап готов идти навстречу потенциальным заказчикам: ученые уже выявили состав колонии бактерий, которые активно поедают полиэтилен.
Заинтересовать клиентов также можно, адаптировав контейнеры под не самые простые климатические условия. Давайте мысленно перенесемся на одно из северных месторождений. Вывозить органические отходы с таких удаленных объектов – не самая простая задача. Но перепад температур в течение года колоссальный: от -50 зимой до +30 летом. Какие же бактерии выживут в такой среде? «Эко Энерджи» ищут ответ на этот вопрос.
Дороже денег
В «Эко Энерджи» отмечают, что деньги, за которые так усердно борются молодые стартапы, – как ни странно, не самый ценный ресурс, который они могут получить. «Я даже не берусь сосчитать, сколько раз мы “пролетали”, не становились финалистами или победителями в разных стартап-конкурсах, – говорит Александр Чеканов. – Но даже если ты не получаешь заветный денежный приз, ты все равно можешь выиграть. Мы ценим любую поддержку: письмо, в котором крупная компания выражает заинтересованность в технологии, соглашения о намерениях, совет, возможность поговорить с реальным бизнесом. И в этом смысле нам очень помогают коллеги из "Энерготехнохаба Петербург": всегда стремятся свести нас с людьми, которые могут быть полезны, рассказывают о потребностях отрасли, которые может закрывать наша разработка, и в какую сторону нам двигаться, чтобы сделать ее максимально полезной для компаний».
Кроме того, «Эко Энерджи» тесно общается с партнером «Энерготехнохаба Петербург» – Институтом нефтегазовых технологических инициатив (ИНТИ). Вместе с ИНТИ команда обсуждает возможность создания стандарта на процессы утилизации органических отходов на объектах нефтегазовых предприятий.
Миллион – на патент
1 870 000 рублей – сумма гранта, который получит стартап «Эко Энерджи» от одного из партнеров «Энерготехнохаба Петербург». Подтверждение будущей выплаты пришло команде на днях. По словам Александра Чеканова, молодые стартапы на начальной стадии развития попадают в замкнутый круг. Инвесторы страхуются и готовы дать деньги только тому проекту, чья идея зарегистрирована как интеллектуальная собственность. Но без финансовых вливаний получить исключительное право на инновацию невозможно. Поэтому новый грант «Эко Энерджи» потратят на оформление международного патента. Заниматься этим команда планирует параллельно с разработкой прототипа своего продукта.